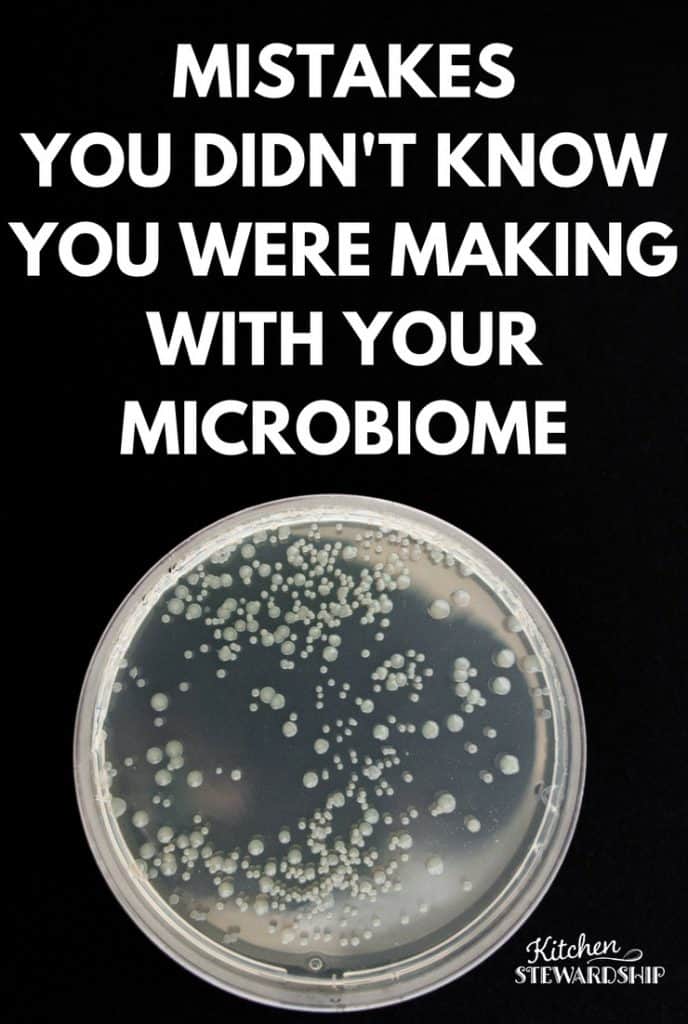
Basics you need to know about your smallest residents, the microbiome. Learn the relationship between birth, antibiotics, processed foods and prebiotics on your gut and overall health.

Yes! It is Possible to Boost Immunity with Diet and Lifestyle
Support your body’s natural immune system with these immune-boosting foods, vitamins, and lifestyle habits for your most vibrant health. Some people have sledding and hot…
Yes! It is Possible to Boost Immunity with Diet and Lifestyle Read More »